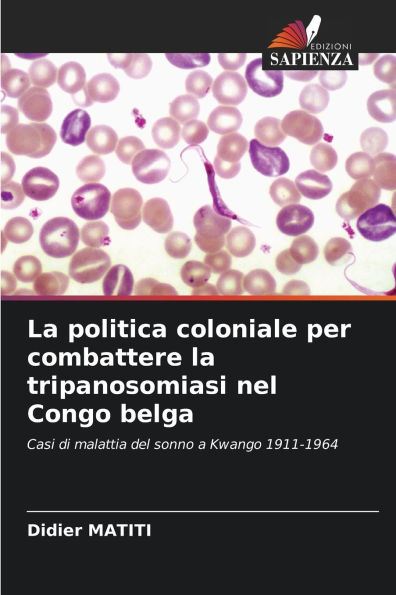
La politica coloniale per combattere la tripanosomiasi nel Congo belga

Home
La Geoeconomia Nella Stabilit� Politica
Barnes and Noble
Loading Inventory...
La Geoeconomia Nella Stabilit� Politica in Franklin, TN
Current price: $48.00

Barnes and Noble
La Geoeconomia Nella Stabilit� Politica in Franklin, TN
Current price: $48.00
Loading Inventory...
Size: OS
Approcciare un'analisi dal concetto di geoeconomia implica la necessità di comprendere questa nuova area di studi che sta attualmente generando un impatto importante sulla conoscenza della geopolitica, nata nel XX secolo.La geoeconomia, nell'ambito delle nuove dinamiche di interdipendenza e globalizzazione dei mercati internazionali, ci permette di comprendere il comportamento e il consolidamento del potere dei Paesi emergenti come grandi potenze economiche all'interno della stessa area geografica e la configurazione di nuovi blocchi economici regionali che stanno cercando di adattarsi alle attuali tendenze del mercato.L'emergere dello Stato di diritto può essere ricondotto alla teoria aristotelica sulla costituzione mista, al pensiero di Marco Tullio Cicerone sulla moderazione, la ragion pratica e la vocazione repubblicana, e a Tommaso d'Aquino sulla moderazione del governo e la sua sottomissione all'etica e al diritto.
Approcciare un'analisi dal concetto di geoeconomia implica la necessità di comprendere questa nuova area di studi che sta attualmente generando un impatto importante sulla conoscenza della geopolitica, nata nel XX secolo.La geoeconomia, nell'ambito delle nuove dinamiche di interdipendenza e globalizzazione dei mercati internazionali, ci permette di comprendere il comportamento e il consolidamento del potere dei Paesi emergenti come grandi potenze economiche all'interno della stessa area geografica e la configurazione di nuovi blocchi economici regionali che stanno cercando di adattarsi alle attuali tendenze del mercato.L'emergere dello Stato di diritto può essere ricondotto alla teoria aristotelica sulla costituzione mista, al pensiero di Marco Tullio Cicerone sulla moderazione, la ragion pratica e la vocazione repubblicana, e a Tommaso d'Aquino sulla moderazione del governo e la sua sottomissione all'etica e al diritto.